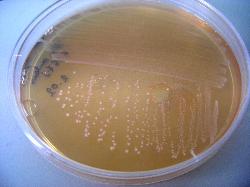

| Streptococcus mutans |
| Streptococcus mutans, Gram staining |
Taxonomy
Morphology
Cultural characteristics
Biochemical characters
Ecology
Pathogenicity
References
Phylum Bacillota (Firmicutes), Class Bacilli, Order Lactobacillales, Family Streptococcaceae, Genus Streptococcus, Streptococcus
mutans Clarke 1924.
Non-groupable by Lancefield antisera. Member of the "Mutans group".
mutans Clarke 1924.
Non-groupable by Lancefield antisera. Member of the "Mutans group".
Gram-positive cocci, 0.5-0.75 µm in diameter, grouped in medium-long chains,
nonmotile. On primary isolation from oral specimens, or in acid conditions in broth
and on some solid media, may form short rods (1.5–3.0 μm in length).
nonmotile. On primary isolation from oral specimens, or in acid conditions in broth
and on some solid media, may form short rods (1.5–3.0 μm in length).
Colonies are small, greywhite; become rough, heaped after 3-4 days; 1 mm diameter;
hard to pick; “run along in front of needle”. Usually alpha-hemolytic or non-hemolytic,
rarely beta-hemolytic. Some strains may form smooth or mucoid colonies.
Facultatively anaerobic, better growing under anaerobic condition or CO2-enhanced
atmosphere. Optimal growth temperature is 37.0 ºC. Growth at 45 ºC is variable. No
growth at 10 ºC. Grow on : Trypticase soy agar with defibrinated sheep blood.
hard to pick; “run along in front of needle”. Usually alpha-hemolytic or non-hemolytic,
rarely beta-hemolytic. Some strains may form smooth or mucoid colonies.
Facultatively anaerobic, better growing under anaerobic condition or CO2-enhanced
atmosphere. Optimal growth temperature is 37.0 ºC. Growth at 45 ºC is variable. No
growth at 10 ºC. Grow on : Trypticase soy agar with defibrinated sheep blood.
Human oral cavity inhabitant. Was first isolated from a carious lesion.
Strains have been isolated from feces.
Grow with 0.25% optocin. Resistant to bacitracin (most strains).
Strains have been isolated from feces.
Grow with 0.25% optocin. Resistant to bacitracin (most strains).
Involved in tooth decay and dental plaque forming. Sucrose is utilized to produce a sticky, extracellular, dextran-based polysaccharide
that allows them to cohere to each other forming plaque. When associated with S. sobrinus, dental caries may have a higher
incidence, especially in children. May cause endocarditis.
that allows them to cohere to each other forming plaque. When associated with S. sobrinus, dental caries may have a higher
incidence, especially in children. May cause endocarditis.
- Holt J.G., Krieg N.R., Sneath P.H.A., Staley J.T. and Williams S.T., 1994. Bergey's Manual of Determinative Bacteriology, Ninth
Edition, Williams & Wilkins, A Waverly Company, Baltimore, pp 527-558. - MITSUGI OKADA, YOSHIKO SODA, FUMIKO HAYASHI, TAKAKO DOI, JUNJI SUZUKI, KAZUO MIURA & KATSUYUKI KOZAI: PCR
detection of Streptococcus mutans and S. sobrinus in dental plaque samples from Japanese pre-school children. J. Med. Microbiol.
- Vol. 51 (2002), 443-447. - Coykendall AL. Proposal to elevate the subspecies of Streptococcus mutans to species status, based on their molecular
composition. Int. J. Syst. Bacteriol. 27: 26-30, 1977. - Richard Facklam: What Happened to the Streptococci: Overview of Taxonomic and Nomenclature Changes. Clinical Microbiology
Reviews, October 2002, p. 613-630, Vol. 15, No. 4. - Robert A. Whiley and Jeremy M. Hardie, 2009. Genus I. Streptococcus Rosenbach 1884, 22AL. In: (Eds.) P.D. Vos, G. Garrity, D.
Jones, N.R. Krieg, W. Ludwig, F.A. Rainey, K.-H. Schleifer, W.B. Whitman. Bergey’s Manual of Systematic Bacteriology, Volume 3:
The Firmicutes, Springer, 655-711.
Positive results for hydrolysis of esculin, leucine aminopeptidase, valine
aminopeptidase, chymotrypsin, phosphoamidase, alpha- or beta-glucosidase,
alpha-galactosidase, alpha-lactosidase, starch hydrolysis (most strains),
Voges-Proskauer reaction, acid production from: arbutin, D-cellobiose, esculin,
galactose, glucose, inulin, lactose, maltose, mannitol, mannose,
N-acetylglucosamine, raffinose, salicin, sorbitol, sucrose and trehalose.
Negative results for alkaline phosphatase, hippurate hydrolysis, urea hydrolysis,
beta-glucosaminidase, glycyltryptophan arylamidase,
N-acetyl-beta-D-galactosaminidase, N-acetyl-beta-D-glucosaminidase,
beta-D-glucuronidase, alpha-fucosidase, beta-D-fucosidase, beta-mannosidase,
beta-maltosidase, alpha-arabinosidase, pyrrolidonyl arylamidase, hyaluronidase,
neuraminidase (sialidase), acid production from: adonitol, arabinose, cyclodextrin,
dulcitol,erythritol, glycerol, glycogen, gluconate, inositol, methyl D-glucoside, methyl
D-mannoside, methyl D-xyloside, melezitose, rhamnose, ribose, sorbose, starch and
xylose.
Variable results for alpha-galactosidase, acid production from amygdalin & melibiose.
aminopeptidase, chymotrypsin, phosphoamidase, alpha- or beta-glucosidase,
alpha-galactosidase, alpha-lactosidase, starch hydrolysis (most strains),
Voges-Proskauer reaction, acid production from: arbutin, D-cellobiose, esculin,
galactose, glucose, inulin, lactose, maltose, mannitol, mannose,
N-acetylglucosamine, raffinose, salicin, sorbitol, sucrose and trehalose.
Negative results for alkaline phosphatase, hippurate hydrolysis, urea hydrolysis,
beta-glucosaminidase, glycyltryptophan arylamidase,
N-acetyl-beta-D-galactosaminidase, N-acetyl-beta-D-glucosaminidase,
beta-D-glucuronidase, alpha-fucosidase, beta-D-fucosidase, beta-mannosidase,
beta-maltosidase, alpha-arabinosidase, pyrrolidonyl arylamidase, hyaluronidase,
neuraminidase (sialidase), acid production from: adonitol, arabinose, cyclodextrin,
dulcitol,erythritol, glycerol, glycogen, gluconate, inositol, methyl D-glucoside, methyl
D-mannoside, methyl D-xyloside, melezitose, rhamnose, ribose, sorbose, starch and
xylose.
Variable results for alpha-galactosidase, acid production from amygdalin & melibiose.

(c) Costin Stoica

| Antibiogram |
| Encyclopedia |
| Culture media |
| Biochemical tests |
| Stainings |
| Images |
| Movies |
| Articles |
| Identification |
| Software |
| R E G N U M PROKARYOTAE |
| Back |
| Streptococcus mutans colonies on BHI Agar |